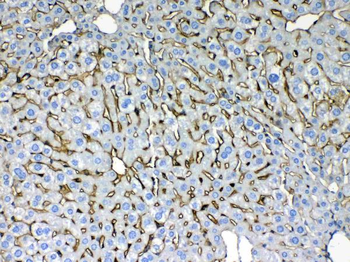
Cytokeratin 8/KRT8 Antibody
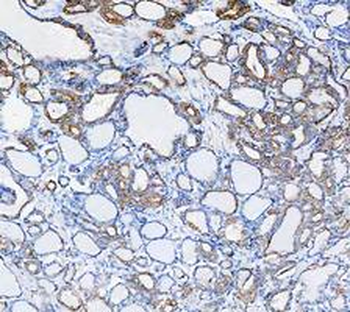
Cytokeratin 8/KRT8 Antibody

You have no items in your shopping cart.
KRT8 Antibody
Description
Images & Validation
−
| Tested Applications | IHC, WB |
|---|---|
| Reactivity | Human |
Key Properties
−| Antibody Type | Recombinant Antibody |
|---|---|
| Host | Rabbit |
| Clonality | Monoclonal |
| Isotype | IgG |
| Clone No. | KRT8.18/2297R |
| Immunogen | Recombinant full-length human KRT8/18 protein |
| Target | KRT8 |
| Source/Expression System | HEK293 cells |
| Molecular Weight | 52.5kDa (CK8); 45kDa (CK18) |
| Conjugation | Unconjugated |
Storage & Handling
−| Storage | Maintain refrigerated at 2-8°C for up to 2 weeks. For long term storage store at -20°C in small aliquots to prevent freeze-thaw cycles. |
|---|---|
| Form/Appearance | 200ug/ml of Ab Purified from Bioreactor Concentrate by Protein A/G. Prepared in 10mM PBS with 0.05% rAlbumin & 0.05% azide. Also available WITHOUT rAlbumin & azide at 1.0mg/ml. |
| Concentration | 200 μg/ml |
| Disclaimer | For research use only |
Alternative Names
−Similar Products
−Cytokeratin 8 Mouse Monoclonal Antibody [orb500822]
FC, IF, IHC-Fr, IHC-P
Mouse, Rat
Human, Mouse, Rat
Mouse
Monoclonal
Unconjugated
200 μg, 200 μl, 100 μl, 50 μlFEN1 Antibody (monoclonal, 6F3F2) [orb1145864]
FC, ICC, IF, IHC, WB
Human, Mouse, Rat
Mouse
Monoclonal
Unconjugated
100 μgCytokeratin 8 Rabbit Polyclonal Antibody [orb10413]
ELISA, IF, IHC-Fr, IHC-P
Gallus, Mouse, Rat
Human
Rabbit
Polyclonal
Unconjugated
100 μl, 200 μl, 50 μlFEN1 Antibody (monoclonal, 7D11D7) [orb1145863]
FC, ICC, IF, IHC, WB
Human, Mouse
Mouse
Monoclonal
Unconjugated
100 μg

Quality Guarantee
Explore bioreagents carefree to elevate your research. All our products are rigorously tested for performance. If a product does not perform as described on its datasheet, our scientific support team will provide expert troubleshooting, a prompt replacement, or a refund. For full details, please see our Terms & Conditions and Buying Guide. Contact us at support@biorbyt.com.
Documents Download
Request a Document
Protocol Information
KRT8 Antibody (orb751340)
Participating in our Biorbyt product reviews program enables you to support fellow scientists by sharing your firsthand experience with our products.
Login to Submit a Review